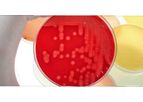
Monitoring & Sampling Service

- Home
- Companies
Refine by
Industries served
- Environmental
- Waste and Recycling
- Water and Wastewater
- Energy
- Soil and Groundwater
- Monitoring and Testing
- Health and Safety
- Construction & Construction Materials
- Oil, Gas & Refineries
- Agriculture
- Manufacturing, Other
- Air and Climate
- Medical / Health Care
- Chemical & Pharmaceuticals
- Mining
- Government
- Metal
- Aerospace & Air Transport
- Food and Beverage
- Automobile & Ground Transport
- Banking & Finance / Insurance / Legal
- Plastics & Resins
- University / Academia / Research
- Pulp & Paper
- Defense
- Electronics and Computers
- Commercial
- Communications / Telecom / Datacom
- Maritime/Shipbuild/Water Transport
- Forestry & Wood
- Real Estate
- Paint
- Textile
- Publishing / Media / Marketing
- Packaging
- Printing
- Logistics
- Glassware
- Dry Cleaning
- Retail
- Travel & Leisure
- Leather & Tanning
- Domestic
- Household Appliances
- Furniture
Environmental Industry Service Provider
3,518 companies found

Service providerbased inCardiff, UNITED KINGDOM
TerraDat was established by Nick Russill and Rob McDonald in the UK and is based since then in Cardiff, the Capital City of Wales. In the beginning our dominant expertise was in seismic refraction, shallow seismic reflection and geo-electrical ...
The Magnetic survey technique is based on mapping localised variations in the Earth’s magnetic field caused sub-surface magnetic materials which range from naturally occurring magnetic minerals to man-made ferrous objects. This leads to a wide ...

Service providerbased inNew York, NEW YORK (USA)
Sims Metal Management Limited is the global leader in metals and electronics recycling. Our leadership position has been built through an uncompromising commitment to safety, customer service and the expertise and loyalty of our extraordinary ...
Sims Metal Management is committed to preventing metal theft. In addition to its commitment to comply with applicable local and state ordinances, the company--at great time and expense--trains employees to identify stolen material and determine who ...

Service providerbased inCharlotte, NORTH CAROLINA (USA)
Lighthouse Lab Services is a leading and trusted end-to-end, full-service medical laboratory consulting and recruiting firm. Our mission is to help clinical laboratories achieve their goals. We work with medical labs and medical lab professionals to ...
Lighthouse Lab Services has a great team of laboratory consultants and other professionals to help you manage your lab effectively. Whether you are starting a new medical lab or looking to grow your current business, we offer laboratories a way to ...

Service providerbased inMorristown, TENNESSEE (USA)
TerraShares is a Green Programs Integrator offering...GreenPath Technical Services, Enhanced Techology Solutions and Green Finance ...
Today your customers increasingly want and need green suppliers to compliment (and reduce the cost of) their own sustainability. Competing in environmentally conscious markets is serious business these days, best addressed by greater operating ...
Service providerbased inHigh Point, NORTH CAROLINA (USA)
A&D Environmental Services, Inc. provides turn-key solutions to our client's environmental and industrial concerns. We do this by developing long-term relationships built on trust, dependable services and fair pricing. Our customers know that we ...
A&D’s emergency response vehicles are equipped with personal protective equipment (PPE), pumps, tank repair kits, cold cutting equipment, hot tap and other equipment necessary to handle a variety of spills. Our Emergency Response Equipment Unit ...
Service providerbased inCannock, UNITED KINGDOM
Nationwide Skips Ltd. is a waste management company that has firmly established itself as the United Kingdom’s leading environmental waste management provider, offering an impressive range of waste management services to the commercial and domestic ...
Nationwide Skips Ltd can help you develop your Site Waste Management Plan. We have worked developed and applied successful strategies for a number of UK construction companies, helping them to make significant reductions in waste volumes and cost. ...

Service providerbased inEssex, UNITED KINGDOM
Houseman Water Hygiene Specialists offer a wide range of water treatment and water hygiene services designed to improve both the safety and cost effectiveness of our customer’s water systems, providing the highest standards in water management. With ...
An integral part of the ACoP L8 requirements is the need to undertake regular monitoring of hot and cold water systems to ensure that they are operating within the guideline ...

Service providerbased inChantilly, VIRGINIA (USA)
ManTech International Corporation has consistently delivered innovative technology and technical services solutions to federal government customers. Today, ManTech has grown to become one of the U.S. government's leading providers of innovative ...
Service providerbased inToledo, OHIO (USA)
Midwest Environmental Control, Inc. of Toledo Ohio has been providing cost-effective, high-quality environmental services to customers around the country since 1983. Spanning over two decades, the company has successfully performed thousands of ...
Underground & above ground storage tank removal and replacement MEC, Inc can remove and/or replace any size fuel storage ...
Service providerbased inFriedrichsdorf, GERMANY
PharmaLex is a leading provider of specialized services for the pharma, biotech and medtech industries. We guide you from early strategic planning activities and non-clinical requirements through clinical development, regulatory submission processes ...
Service providerbased infort lauderdale, FLORIDA (USA)
Fort Lauderdale's Same Day Dumpster Rental provides south Florida with weekly and long term waste management and dumpster rental solutions. We service all of Miami-Dade county, Broward County, Palm Beach, and Martin County regions. Our most ...
Same Day Dumpster Rental is providing local roll of services and dumpster rental services in the Dallas, Texas region. We service the entire Dallas/Fort Worth region and are glad to help you with all of your recycling and waste management needs. ...

Service providerbased in, SLOVAKIA
Ekolumi is young progressive company, which works in the field of waste management, hazardous wastes management. We create maps layouts with chart documentation in the GIS environment as well. It is the company with a realy innovative approach to ...
Pressing and sorting pack materials by press Presoma LP 80 VH – PET, paper, cartoon, clingfilm. Pressing and sorting industrial materials – various industrial plastics, foil, paper, ...

Service providerbased inMurrieta, CALIFORNIA (USA)
We provide mold and asbestos inspections and testing services in Murrieta and Temecula. Our mold inspectors are friendly, professional and knowledgeable. We can help you. We have over two decades of experience and a trusted reputation for ...
Mold inspections can help identify if the source of your problem is mold, especially if there are high concentrations of mold spores/particles in the air. A mold inspection can help identify if you have mold or microbial growth or contamination in ...

Service providerbased inSatellite Beach, FLORIDA (USA)
We help Quick Service Restaurants, Full Service Restaurants, Retail Stores, Schools, Commercial Businesses and Bowling Alleys reduce their trash costs by 40-60%. Provide a safe and manageable waste solution for all that recovers lost profits. What ...
Dining Room Trash Transfer Container: Improves QSC (Quality, Service and Cleanliness) focus in the front of the house. Blue colored container for designated use. Clean, slip free movement of trash from the dining room to back of the house. Retains ...

Service providerbased inMemphis, TENNESSEE (USA)
We Provide a Wide Range of Landscape Services. Since opening its doors in 1987, Michael Hatcher & Associates has become one of the most respected names in the local landscape industry. Growing from a three man sole proprietorship to a multi-division ...
Service providerbased inOklahoma, OKLAHOMA (USA)
Standard Testing and Engineering Company was founded in as a professional engineering firm specializing in materials testing and engineering for the construction and manufacturing industries. Standard Testing has traditionally provided a broad scope ...

Service providerbased inConway, ARKANSAS (USA)
Crafton Tull has been contributing to the built environment for over 50 years. That longevity, coupled with investments in technologies and sustainable design practices confirms that we are well crafted to lead our industry well into the ...

Service providerbased inWellesley, ONTARIO (CANADA)
MWI Silo Systems builds reinforced concrete silos for a wide variety of products including grains, wheat shorts, meals, coal, fly ash, sand, cement, and wood waste. MWI also constructs specialty towers for observation, housing, anerobic digesters ...
Non or semi free-flowing bulk material usually requires a reclaim system. MWI is the exclusive Canadian representative of the Weaver reclaimers. We have installed their system for more than 30 years. Capacities are tailored to the customer's needs. ...

Service providerbased inIndianapolis, INDIANA (USA)
HIS Constructors, Inc. a leader in providing civil construction, environmental remediation, hydrovac excavation and industrial ...
HIS performs a wide variety of civil construction projects including bridge construction, water, sanitary and storm sewers, concrete construction, mass excavation and grading, demolition, site work/development, sheeting and ...

Service providerbased inBrownwood, TEXAS (USA)
AIT Services, Inc. Patented 'V Series' Evaporators have been longtime front-runner in the manufacturing Wastewater Evaporation Systems and Sludge Dehydration Equipment. AIT’s innovative approach, and long successful history producing some of the ...